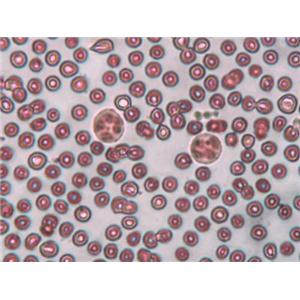

细胞染色缓冲液
细胞染色缓冲液
询价
更新时间:2026/04/05
 固定&通透试剂盒
固定&通透试剂盒
询价
更新时间:2026/04/05
 淋巴细胞刺激合剂,500X
淋巴细胞刺激合剂,500X
询价
更新时间:2026/04/05
 Fc受体饱和试剂
Fc受体饱和试剂
¥700 元
更新时间:2026/04/05